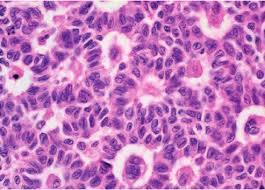

What is the name and cause of damage to the superior trunk of the brachial plexus
- Erb-Duchenne Palsy (“waiter’s tip”)
- Injury to superior trunk (C5-C6)
- Causes:
- Lateral neck traction during delivery of babies
- Trauma in adults
Muscle/functions innervated by superior gluteal m/
- Innervates:
- Hip abduction and medial rotation of thigh = tensor fasciae lata, gluteus minimus, gluteus medius
- Lesion:
- Posterior hip dislocation, polio
- Leads to Trendelenburg sign:
- Contralateral hip drops when you are standing on leg ipsilateral to lesion
Muscle/function innervated by inferior gluteal
- Innervates:
- Hip extension and lateral rotation of thigh à gluteus maximus
- Lesion:
- Posterior hip dislocation
- Hard time getting up from sitting position
Damage to what nerve caused Trendelenberg gait
Superior gluteal (respsonsible for gluteus medius and minimus, which do hip abduction)
What nerve gets damaged with knee injury
Tibial (is located posterior to knee)
What nerve gets damaged with fibula neck fracture
Deep or superficial peroneal
What nerves are involved in each of the following reflexes?
- Achilles
- Patellar
- Biceps/brachioradialis
- Triceps
- Cremasteric
- Anal wink
Clinical reflexes:
- Achilles reflex = S1, S2 (“buckle my shoe”)
- Patellar reflex = L3, L4 (“kick the door”)
- Biceps and brachioradialis reflexes = C5, C6 (“pick up sticks”)
- Triceps reflex = C7, C8 (“lay them straight”)
- Cremasteric reflex = L1, L2 (“testicles move”)
- Anal wink reflex = S3, S4 (“winks galore”)
Innervation of teres minor
Axillary nerve
Defect and presentation of Atazia telangectasia
- Immunodeficiency = decreased T-cells and IgA
- Defect in ATM gene = failure to repair DNA double strand breaks = cell cycle arrest
- THINK: the “T” in aTaxia and Telangiectasia is a dsDNA
- Triad:
- · Cerebellar defects – ataxia
- · Spider angiomas – telangiectasia
- · IgA deficiency
Structures formed by meso- and metanephros
- Mesonephros
- Forms temporary kidney during 1st trimester
- Later contributes to male genital system – Wolffian ducts
- Caudal end becomes the ureteric bud which gives risk to ureter, pelvises, calyces, collecting ducts
- Metanephros
- Interaction with the ureteric bud (caudal portion of mesonephros) induces differentiation and formation of glomerulus, Bowman’s space, proximal tubule, loop of Henles, and distal convoluted tubule
What type of drug is Chlordiazopoxide
Benzo
Histology of granulosa-theca cell tumor
Call-Exner bodies
Granulosa cells arranged haphazardly around collections of eosinophilic fluid, resembling primordial follicles
Histology of Sertoli-Leydig cell tumor
Reinke crystals

What does HELLP syndrome stand for and what is the reasoning behind the symptoms
- Stands for:
- H - Hemolysis (anemia)
- EL - Elevated Liver enzymes (RUQ pain, jaundice)
- LP - Low Platelets (bruising bleeding)
- Preeclampsia + thrombotic microangiopathy
- Hemolysis = thrombi causing schistocytes
- Liver enzymes = lack of RBCs leads to infarction of liver tissue
- Platelets = all used up in thrombi
What is Meigs syndrome
Triad of: ovarian fibroma, ascites, pleural effusion
Mutation and presentation of Williams syndrome
Microdeletion of long arm of chromosome 7 (deletion includes elastin gene)
“Elfin” facies, intellectual disability, hypercalcemia, well-developed verbal skills, extreme friendliess with strangers
THINK: Will Ferrel in the movie elf
Describe presentation of Tuberous sclerosis
- Due to mutated hamartin (or tuberin) gene
- TSC1/TSC2 mutation on chromosome 16
- Triad:
- Angiofibromas, mental retardation, seizures
- Vs. VHL which is angiomatosis
- Angiofibromas, mental retardation, seizures
- Other symptoms: Ash-leaf spots, hamartomas of CNS and skin, angiomyolipoma
- Incomplete penetrance and variable presentation
What is the equation for incidence
- Incidence = number of new cases during a specific time period
- (# of new cases) / (# of people at risk)
Equation for number needed to treat
1/ARR
NOT 1 - ARR!!
Differentiate between case-control study and cohort study
Case control = compare a group with disease to group without disease and look for prior exposures/risk factors (is retrospective)
Cohort study = compare a group with risk factor to a group without risk factor and look for likelihood of disease (can be prosepective or retrospective)
Describe difference between T-test, ANOVA, and chi-square
- T-test:
- Tests for differences between means of 2 groups with continuous variables
- THINK: Tea is meant for 2
- ANOVA:
- Tests for differences between means of 3 or more groups with continuous variables
- THINK: 3 words in “Analysis Of Variance”
- Chi-square:
- Checks differences between 2 or more percentages or proportions of categorical outcomes (not mean values)
- THINK: Chi-tegorical
Medicare vs. Medicaid
Medicare = elderly + those with certain conditions and end-stage disease
Medicaid = low income
What is a Cushing ulcer
Gastric ulcer due to brain injury
Brain injury = increased vagal stimulation = increased ACh = increased H+ production
What is Menetrier disease
- Menetrier disease:
- Gastric hyperplasia of mucosa cells of the stomach
- Leads to hypertrophied rugae which look like brain gyri
- Atrophy of parietal cells à decreased gastric acid production
- Increased risk of gastric carcinoma
- Gastric hyperplasia of mucosa cells of the stomach




